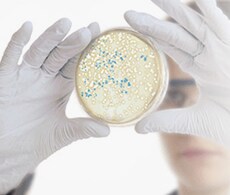
TA Cloning Kits

Search
Search
Invitrogen TA Cloning technology greatly simplifies traditional restriction and ligation cloning with a one-step cloning strategy that eliminates the need for any enzymatic modifications of the PCR product and not require the use of primers that contain restriction enzyme sites.
Invitrogen TA Cloning Kits rely on the complementary bases of adenine (A) and thymine (T) on different DNA fragments to hybridize together. PCR products are amplified using a Taq DNA polymerase which adds a single deoxyadenosine to the 3' end of the product. The linearized vectors supplied in TA cloning kits have a complimentary 3´ deoxythymidine (T) residues allowing the insert to ligate into the vector efficiently.
With the addition of the Invitrogen ExpressLink T4 DNA Ligase into TA Cloning Kits, ligation can be performed at room temperature in only 15 minutes with reactions typically yielding >80% recombinants containing inserts.
TA Cloning kits are available with a choice of Invitrogen pCR 2.1 and pCR II vectors. The T7 and Sp6 promoters of the pCR II vector allow in vitro transcription of the insert to produce sense or anti-sense products.
TA Cloning kits are available without competent cells (K2020-20 and K2020-40) or with Invitrogen One Shot INVαF’ Chemically Competent E. coli (K2000-01 and K2000-40), and One Shot TOP10F’ Chemically Competent E. coli (K2040-01 and K2040-40) in both 20 and 40-reaction pack sizes.
For TA Cloning with the pCR II Vector (dual promoter) kits are available without competent cells (K2750-20 and K2750-40), with One Shot INVαF’ Chemically Competent E. coli (K2050-01 and K2050-40), and One Shot TOP10F’ Chemically Competent E. coli (K2060-01 and K2060-40) in both 20 and 40-reaction pack sizes.
TA Cloning Kits outperform ‘Competitor P’ in performance and value.
| TA Cloning Kits | Competitor P | |
|---|---|---|
| Cloning efficiency | 80% (with control) | 60% (with control) |
| Time for ligation | 15 minutes | 1 hour |
| Temperature for ligation | Room temperature | Room temperature |
| PCR clean-up required? | No | Recommended |
| Selection antibiotic | Kanamycin & Ampicillin | Ampicillin only |
| Kit contents | ||
| Vector | ||
| Ligation Buffer | ||
| Control Insert DNA | ||
| dNTPs | ||
| Sterile Water | ||
| Control DNA template | ||
| PCR Buffer | ||
| Control PCR Primers | ||
Thermostable polymerases containing extensive 3´ to 5´ exonuclease activity, such as Invitrogen Platinum SuperFi, do not leave 3´ A-overhangs. PCR products generated with Taq polymerase have a high efficiency of cloning in the TA Cloning system because the 3´ A-overhangs are not removed. However, if you use a proofreading polymerase or wish to clone blunt-ended fragments, you can add 3´ A-overhangs by incubating with Taq at the end of your cycling program.
Alternatively, you may want to try the Invitrogen Zero Blunt PCR Cloning Kit. This kit offers efficient cloning of blunt-end PCR products generated using thermostable, proofreading polymerases.
Cloning Support Center
Find tips, troubleshooting help, and resources for your cloning applications
Cloning Education
Learn about PCR cloning strategies and subcloning approaches
PCR Education
Review the principles of PCR, components, cycling parameters, methods, and applications
For Research Use Only. Not for use in diagnostic procedures.